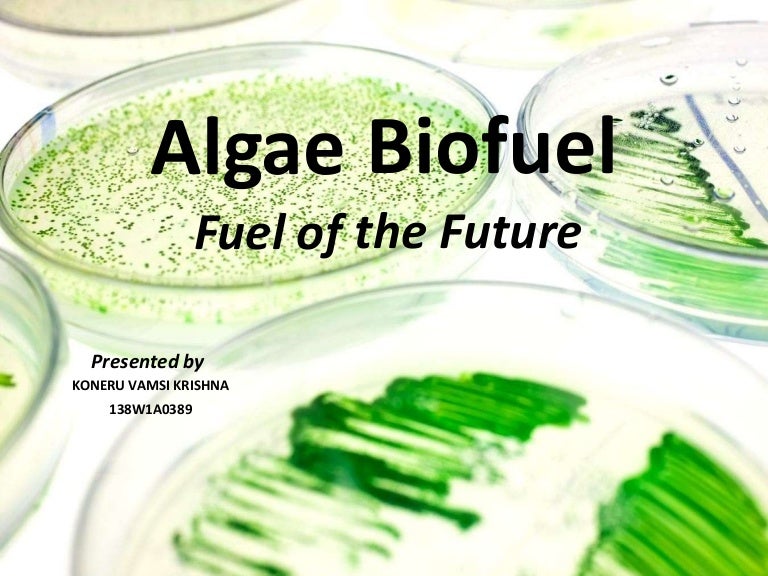

When you need a heartier snack, this mayo-free chicken salad might be the answer. Cashew butter is loaded with protein while celery is low in calories - for a little extra sweetness, swap in some dark chocolate chips for raisins! 4.
Make snack time fun for children and adults with these ants on a log. Perfect as an after-school snack for the children or just as an easy way to eat more nutrient-rich salmon, these sticks get coated in seasoned gluten-free breadcrumbs and baked for a healthy protein snack that takes just minutes to prepare. Photo: Almond Coconut Protein Bars With Hemp Seeds / Running on Real Food 2. What makes these some of the best high-protein snacks? There is a mix of high-protein, low-carb snacks and high-protein, low-fat snacks here, and best of all, they’re all healthy high-protein snacks to boot! You’ll love these healthy, natural high-protein snacks when you need to quell hunger between meals, need a post-workout boost or want to serve something healthy - and delicious - to your family. There’s no need to limit protein intake to your three main meals. Go higher for muscle building or fat loss. How much protein do I need a day? In general, consuming about 50 percent of your body weight in grams of protein per day is ideal. Protein not only forces your body to use more calories during digestion than carbs, but it also helps build and maintain muscle and keeps your body from storing extra fat.

In the battle of the bulge, protein’s ability to jump-start metabolic levels makes it an ingredient worth including in both meals and snacks. Do you need a snack that will help improve muscle tone, keep energy levels steady and boost your metabolism? Then it’s time you introduce high-protein snacks into your diet.Īs an essential nutrient in our bodies, our bodies need enough high-protein foods to run smoothly.


 0 kommentar(er)
0 kommentar(er)
